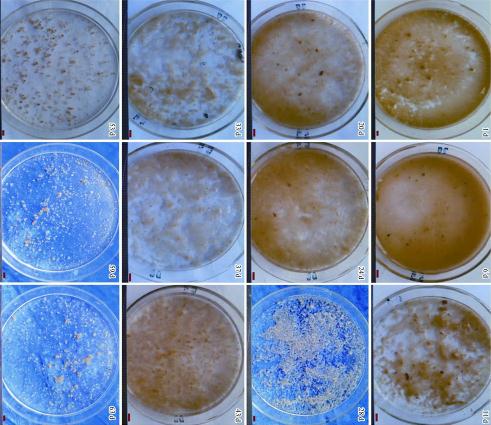
59cb54a2918cc25c29ddbf676324ba02.jpg

服务热线:13986108487
邮箱地址: 13986108487@139.com
公司地址:武汉市汉阳区绿地国博财富中心A座2508
工业、农业的快速发展,城镇人口的增长产生了大量的工业污水和生活废水,很多的污水尤其是工业废水不经过加工处理或者处理的达不到排放标准要求,就直接排放到河流湖泊当中,造成水资源的严重污染。通过专家、学者的不断研究,发现采用生物膜法来处理化工污水比活性污泥法达到的效果更好,好氧颗粒污泥就是生物膜的一种特殊形态,是目前处理污水所采取的措施中最有发展前途且效果最好的生物技术之一。本文对好氧颗粒污泥的形成原理以及在化工污水处理过程中的应用进行了阐述分析。

1好氧颗粒污泥概述
好氧颗粒污泥英文缩写为AGS,是一种比较特殊的颗粒状的生物组合体,它主要是利用生物自凝聚的特性而形成的一种颗粒状活性污泥。好氧颗粒污泥结构严密有规律,具有较强的沉降性能,在处理污染物方面能达到非常明显的效果。因为微生物本身固有的自固定性的性能特点,即便是在动态的条件下也能够很好进行凝固,形成团聚的生物体,而且不会出现膨胀现象,也不会降低水质。1980年,在污水处理的研究上发现了厌氧颗粒污泥,在采用厌氧颗粒污泥进行污水处理时发现其在处理污水的过程中会发生很高的温度反应,而且时间特别长,对于低碳类、氮磷含量高的污水达不到很好的去除效果。专家们在20世纪90年代发现了好氧颗粒污泥,并且将其在污水处理过程中进行使用,结果表明,好氧颗粒污泥能够将高浓度的有毒有机物质,以及氮磷含量非常高的污水处理得非常干净,一些重金属和乳制品废水也能达到很好的效果,于是好氧颗粒污泥技术成为环境工程领域内的研究热点和焦点。
2好氧顆粒污泥的特点
好氧颗粒污泥的培养比较困难,受到的条件限制很多,而且不同状况下培养出的好氧颗粒污泥的大小、颜色以及相应的性能都不相同。
2.1色泽和颗粒
好氧颗粒污泥的外形非常有规则,一般为圆形或椭圆形,表面颜色为浅黄色或者橘黄色并且有丰富的孔隙。颗粒污泥的颗粒直径会不断地变大,随着直径的增加,污泥的下沉速度也会跟着加快,污泥的密度和疏水性也会随之加大,这时颗粒污泥的体积是在逐渐减小的。当颗粒污泥的直径超过4㎜之后阻力加大,对微生物的繁殖生长以及多聚物的分泌就会产生影响,最终导致颗粒污泥的表皮破裂,逐渐形成絮状活性污泥。所以在应用好氧颗粒污泥技术对化工污水进行处理时必须要掌握好颗粒污泥的颗粒大小和生物活性特征。
2.2沉降性能
好氧颗粒污泥的密度、体积指数以及污泥的沉降比指数综合数值都在最佳状态值范围,虽然含水率较高超过了97%,但是并不影响沉降速率,好氧颗粒污泥的沉降速度是絮状污泥沉降速度的5~6倍,所以即便是水力负载很强的环境下依然具有非常高的运行状态和效率。
2.3微生物多样性
颗粒污泥内部形成分为很多的区域,有好氧区、缺氧区和厌氧区,微生物的有氧代谢能降解有机污染物,还可以氧化污水中含有氨氮的物质。氧化后的氨氮成分逐渐扩散到缺氧区和厌氧区,在这里微生物作为电子受体对其进行代谢,从而降低污水中的氮元素。同时颗粒污泥中的含有的微生物能有效地去除污水中的COD、BOD和TN。还能够降低污水池中的污染物体积,从而降低了污水处理厂对占地面积的需求。
3好氧颗粒污泥的形成
培养好氧颗粒污泥受到的条件限制特别多,必须控制好对其产生影响的各类因素,最为重要的影响因素有:污泥种泥的来源、反应器、底物成分、有机负荷、进水方式以及污泥沉淀的时间、在水里的剪切力。好氧颗粒污泥培养过程中,影响污泥颗粒化的是种泥的来源、底物成分和SBR,只有控制好这三项影响因素才能保证污泥的颗粒化。
通过反复的研究和实践得出,培养好氧颗粒污泥最好的种泥是活性污泥。活性污泥中含有大量的微生物群落,這是形成好氧颗粒污泥的重要条件。在排放出来的化工污水中含有的微生物有亲水性的也有疏水性的,亲水性微生物不容易被污泥絮体吸附,因此种泥中含有的疏水性微生物自然是越多越好,好氧颗粒污泥也就更加容易成功的培养出来,其沉降的性能就更强。在培养颗粒污泥的过程中,正二价、三价的离子和带负电的细菌结合之后,形成微生物细胞核。通过这些正负离子结合的方式培养好氧颗粒污泥过程比较繁琐,而且要求的技术水平较高,一定要对各类因素的掌握要恰到好处,一些相关的正、负离子以及时间和器具的掌握必须严格的按照参数操作执行,确保培养出的颗粒污泥的稳定性能。
4好氧颗粒污泥的应用
好氧颗粒污泥应用到化工污水处理中,因为其较强的沉降性能,EPS所具有的耐冲击和耐毒性,通过对微生物原理的利用,微生物的自固定化所具备的可生物添加性,是处理污水的关键。
4.1有毒有机废水的处理
基于好氧颗粒污泥的密度和密实性结构,对有毒物质的抵抗能力非常强,化工污水中会含有大量的微量元素物质,有些是具有一定的毒性的,如苯酚、硝基酚等含有酚类物质的污水,这些酚类对水中的生物具有非常强的毒性,浓度很低的苯酚排放到河流湖泊中都会导致微生物死亡。好氧颗粒污泥应用到含有苯酚物质的污水中,对苯酚的比降解速率是非常高的,即便是苯酚浓度达到每升1900㎎时,仍然能达到降解效果,好氧颗粒污泥对苯酚的比降解速率最高可达1.18 g苯酚/g VSSd。对硝基酚产生的作用也是一样的。除了含有酚类物质的废水外,好氧颗粒污泥还能有效地处理嘧啶类废水、含有甲基叔丁基醚类元素物质的废水以及三级及甲醇类污水。

4.2乳制品废水的处理
乳制品废水中含有很多营养物质,人们把过多的对污水、废水处理的研究精力都倾注于人工有机污水处理的研究上,而好氧颗粒污泥用于乳制品废水的处理上则开创了新的研究焦点。把好氧颗粒污泥用在乳制品工厂排放的污水当中,当充水比达到50%时,去除COD的概率仍然能够达到90%,对于氮的去除率可以达到80%,总磷达到67%。
4.3对重金属燃料废水的处理
采用生物技术处理污水、废水时会添加一些添加剂来促进生物的吸附能力,常用做生物吸附剂的有藻类、真菌、活性污泥等,目前采用的生物吸附剂多是悬浮微生物,但因为其具有不稳定性、吸附后不容易分离和再生困难等弊端,对重金属废水和染料废水的处理效果不是很好。好氧颗粒污泥则能有效地解决这些问题,强大的吸附能力能够处理高浓度重金属废水,同时对阳离子和染料、荧光剂都有很强的吸附能力。
4.4核废料废水的处理
好氧颗粒污泥作为新型的生物材料可以有效地去除水中溶解性的铀,对于铀的吸附能力会根据铀的pH值的变化随之加强或减弱,好氧颗粒污泥吸附铀的同时还会释放出金属阳离子,具有离子交换能力,因此处理废水中低浓度铀的效果是其他物理化学方法都达不到的。
5结论
综上所述,好氧颗粒污泥技术和传统的活性污泥技术相比,对污水处理的效果远远高于传统的活性污泥技术。好氧颗粒污泥技术所具有的强大优势和对污水、废水处理取得的效果,已经引起了相关部门的重视,成为当今污水处理方法研究的焦点。但是好氧颗粒污泥培养上所受到的条件限制因素太多,不容易做好控制工作,所以好氧颗粒污泥在污水处理上存在一定的难度。虽然好氧颗粒污泥的数学模型存在不完整性,研究方面也没有规律性和可操作性,然而其在污水尤其是化工污水处理上有明显效果和优势。通过不断地研究发现,加强好氧颗粒污泥的培养方法,采用这项处理技术可以提高废水中污染物的负荷,缩短有害物质的停留时间。同时由于好氧颗粒污泥的自身的密度和结构,还能够有效地降低污水处理池的占地面积。好氧颗粒污泥工艺技术的研发和应用,开启了污水处理的新篇章,不但有效地缓解了环境污染的严重事态,也促进了相关行业的发展,为保护水资源做出了巨大的贡献。